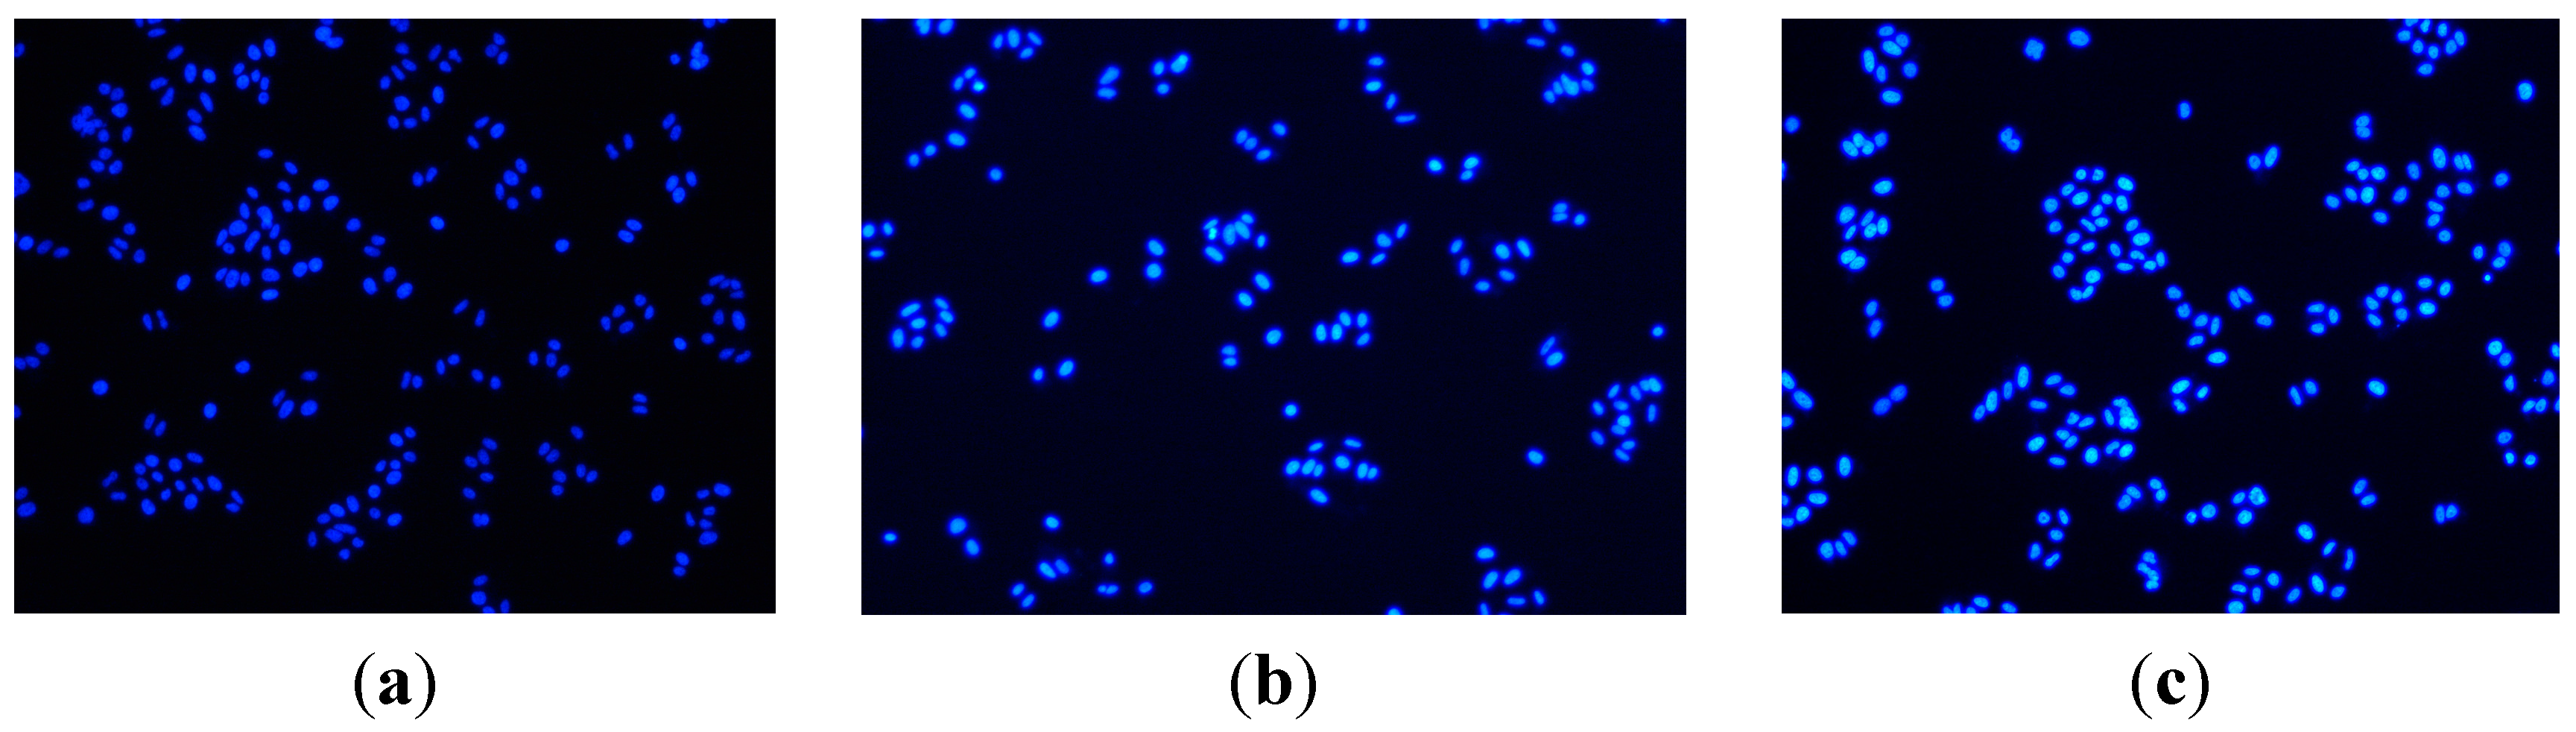
Ijms 16 14571 g002 1024

3.1. Chemistry
Experimental: NMR spectra were recorded on a BRUKER AVANCE 400 NMR spectrometer (Bruker, Rheinstetten, Germany) in CDCl3. Mass spectra were determined on a FTMS ESI spectrometer (Thermo, Waltham, MA, USA).
General procedure for the preparation of compounds 8 and 9: l-amino acid (1 mmol) and phthalic anhydride (1.2 mmol) were added to CH3COOH (25 mL) and the mixture was stirred at 50 °C for 12 h to offer compound 2. Compound 2 (1 mmol) added to dry CH2Cl2 (15 mL) was stirred at 0 °C and oxalyl chloride (1.5 mmol) was dripped into the mixture and stirred at room temperature for 6 h. After the reaction, the solvent and excess oxalyl chloride was evaporated under reduced pressure. Aromatic primary amines (1 mmol) and triethylamine (0.5 mmol) were added to the mixture and stirred at room temperature for 0.5 h. After the reaction, the solvent was evaporated under reduced pressure, and the crude product was purified by chromatography on silica gel eluted with petroleum ether/ethyl acetate (V:V = 6:1) to offer compound 4. Compound 4 (1 mmol) and hydrazine hydrate (3 mmol) were added to ethanol (15 mL) and the mixture was stirred at room temperature for 8 h. After the reaction was completed, the solvent was evaporated under reduced pressure, and the crude product was purified by chromatography on silica gel eluted with petroleum ether/ethyl acetate (V:V = 3:1) to obtain compounds 5. DHAA (1 mmol) added to dry CH2Cl2 (15 mL) was stirred at 0 °C and oxalyl chloride (1.5 mmol) was dripped into the mixture and stirred at room temperature for 6 h. After the reaction, the solvent and excess oxalyl chloride was evaporated under reduced pressure to offer compound 6. Compound 6 (1 mmol) and KSCN (1.2 mmol) were added to toluene (15 mL) and the mixture was stirred at 110 °C for 12 h to offer compound 7. Compounds 5 (1 mmol) and compound 7 (1 mmol) were added to CH2Cl2 (15 mL) and the mixture was stirred at room temperature for 0.5 h. After the reaction, the solvent was evaporated under reduced pressure, and the crude product was purified by chromatography on silica gel eluted with petroleum ether/ethyl acetate (V:V = 6:1) to offer compounds 8a–8o and 9a–9o.
(1R,4aS)-7-Isopropyl-1,4a-dimethyl-N-(((R)-1-oxo-1-(phenylamino)propan-2-yl)carbamothioyl)-1,2,3,4,4a,9,10,10a-octahydrophenanthrene-1-carboxamide (8a). Yields 85.52%; 1H NMR (400 MHz, CDCl3): δ 11.13 (d, J = 7.5 Hz, 1H, NH), 8.71 (s, 1H, NH), 8.61 (s, 1H, NH), 7.58 (d, J = 7.6 Hz, 2H), 7.34 (t, J = 8.0 Hz, 2H), 7.18 (d, J = 8.2 Hz, 1H), 7.13 (s, 1H), 7.04 (d, J = 6.4 Hz, 1H), 6.91 (s, 1H), 5.16–5.10 (m, 1H), 2.95–2.80 (m, 3H), 2.36 (d, J = 13.3 Hz, 1H), 2.10 (d, J = 12.5 Hz, 1H), 1.80–1.69 (m, 5H), 1.61 (d, J = 6.9 Hz, 3H, CH3), 1.53–1.46 (m, 2H), 1.36 (s, 3H, CH3), 1.25 (s, 6H, 2 × CH3), 1.23 (s, 3H, CH3). 13C NMR (100 MHz, CDCl3): δ 180.1, 179.5, 168.5, 146.1, 146.1, 137.6, 134.2, 129.0, 126.9, 124.4, 124.1, 123.9, 119.9, 55.2, 48.6, 45.2, 37.6, 37.1, 37.0, 33.4, 29.7, 25.1, 23.9, 21.4, 18.4, 16.7, 16.1. HR-MS (m/z) (ESI): calcd for C30H39N3O2S [M − H+]: 504.26847; found: 504.26982.
(1R,4aS)-7-Isopropyl-1,4a-dimethyl-N-(((R)-1-oxo-1-(o-tolylamino)propan-2-yl)carbamothioyl)-1,2,3,4,4a,9,10,10a-octahydrophenanthrene-1-carboxamide (8b). Yields 84.32%; 1H NMR (400 MHz, CDCl3): δ 11.10 (d, J = 7.7 Hz, 1H, NH), 8.63 (s, 1H, NH), 8.22 (s, 1H, NH), 7.87 (d, J = 7.7 Hz, 1H), 7.21 (d, J = 8.4 Hz, 1H), 7.06 (d, J = 8.2 Hz, 1H), 7.00 (d, J = 8.0 Hz, 2H), 6.88 (s, 1H), 6.71–6.65 (m, 1H), 5.17–5.13 (m, 1H), 2.93–2.77 (m, 3H), 2.32 (d, J = 12.9 Hz, 1H), 2.27 (s, 3H, CH3), 2.07 (d, J = 10.7 Hz, 1H), 1.80–1.66 (m, 5H), 1.59 (d, J = 6.9 Hz, 3H, CH3), 1.50–1.42 (m, 2H), 1.32 (s, 3H, CH3), 1.22 (d, J = 2.8 Hz, 6H, 2 × CH3), 1.21 (s, 3H, CH3). 13C NMR (100 MHz, CDCl3): δ 179.8, 179.4, 168.6, 146.1, 145.9, 135.5, 134.1, 130.4, 128.8, 126.8, 126.5, 124.0, 122.6, 121.2, 118.4, 55.1, 48.5, 45.1, 37.5, 36.9, 36.9, 33.3, 29.6, 25.0, 23.9, 21.3, 18.1, 17.3, 16.8, 16.0. HR-MS (m/z) (ESI): calcd for C31H41N3O2S [M − H+]: 518.28412; found: 518.28514.
(1R,4aS)-7-Isopropyl-1,4a-dimethyl-N-(((R)-1-oxo-1-(p-tolylamino)propan-2-yl)carbamothioyl)-1,2,3,4,4a,9,10,10a-octahydrophenanthrene-1-carboxamide (8c). Yields 81.26%; 1H NMR (400 MHz, CDCl3): δ 11.11 (d, J = 7.5 Hz, 1H, NH), 8.59 (d, J = 4.3 Hz, 2H, NH), 7.43 (d, J = 8.4 Hz, 2H), 7.15 (d, J = 8.2 Hz, 1H), 7.10 (d, J = 8.2 Hz, 2H), 7.01 (dd, J = 8.2, 1.7 Hz, 1H), 6.88 (d, J = 1.3 Hz, 1H), 5.08 (dd, J = 13.5, 7.3 Hz, 1H), 3.00–2.74 (m, 3H), 2.33 (d, J = 12.3 Hz, 1H), 2.30 (s, 3H, CH3), 2.07 (d, J = 10.6 Hz, 1H), 1.79–1.64 (m, 5H), 1.58 (d, J = 6.9 Hz, 3H, CH3), 1.51–1.43 (m, 2H), 1.33 (s, 3H, CH3), 1.23 (s, 6H, 2 × CH3), 1.21 (s, 3H, CH3). 13C NMR (100 MHz, CDCl3): δ 179.8, 179.4, 168.4, 146.1, 146.0, 135.0, 134.2, 134.0, 129.4, 126.9, 124.0, 123.9, 119.9, 55.2, 48.6, 45.1, 37.5, 37.0, 37.0, 33.4, 29.6, 25.1, 23.9, 21.4, 20.8, 18.4, 16.8, 16.0. HR-MS (m/z) (ESI): calcd for C31H41N3O2S [M − H+]: 518.28412; found: 518.28516.
(1R,4aS)-N-(((R)-1-((2-Chlorophenyl)amino)-1-oxopropan-2-yl)carbamothioyl)-7-isopropyl-1,4a-dimethyl-1,2,3,4,4a,9,10,10a-octahydrophenanthrene-1-carboxamide (8d). Yields 84.16%; 1H NMR (400 MHz, CDCl3): δ 11.15 (d, J = 7.4 Hz, 1H, NH), 8.67 (s, 1H, NH), 8.51 (s, 1H, NH), 8.36 (d, J = 8.2 Hz, 1H), 7.36 (dd, J = 8.0, 1.4 Hz, 1H), 7.26 (d, J = 7.2 Hz, 1H), 7.15 (d, J = 8.2 Hz, 1H), 7.05 (d, J = 9.1 Hz, 1H), 7.01 (d, J = 8.3 Hz, 1H), 6.89 (s, 1H), 5.20–5.14 (m, 1H), 2.92–2.79 (m, 3H), 2.33 (d, J = 13.3 Hz, 1H), 2.09 (d, J = 12.4 Hz, 1H), 1.83–1.68 (m, 5H), 1.62 (d, J = 7.0 Hz, 3H, CH3), 1.52–1.46 (m, 2H), 1.34 (s, 3H, CH3), 1.23 (s, 6H, 2 × CH3), 1.21 (s, 3H, CH3). 13C NMR (100 MHz, CDCl3): δ 180.0, 179.4, 168.7, 146.0, 145.9, 134.1, 134.1, 129.0, 127.5, 126.8, 124.9, 123.9, 123.9, 123.1, 121.7, 55.4, 48.5, 45.1, 37.5, 36.9, 36.8, 33.3, 29.6, 25.0, 23.9, 21.3, 18.3, 17.1, 16.0. HR-MS (m/z) (ESI): calcd for C30H38ClN3O3S [M − H+]: 538.22950; found: 538.23111.
(1R,4aS)-N-(((R)-1-((4-Chlorophenyl)amino)-1-oxopropan-2-yl)carbamothioyl)-7-isopropyl-1,4a-dimethyl-1,2,3,4,4a,9,10,10a-octahydrophenanthrene-1-carboxamide (8e). Yields 84.78%; 1H NMR (400 MHz, CDCl3): δ 11.10 (d, J = 7.5 Hz, 1H, NH), 8.86 (s, 1H, NH), 8.60 (s, 1H, NH), 7.51 (d, J = 8.9 Hz, 2H), 7.29–7.26 (m, 2H), 7.15 (s, 1H), 7.02 (dd, J = 8.2, 1.7 Hz, 1H), 6.89 (d, J = 1.4 Hz, 1H), 5.11–5.07 (m, 1H), 2.93–2.80 (m, 3H), 2.34 (d, J = 13.3 Hz, 1H), 2.07 (d, J = 12.0 Hz, 1H), 1.82–1.69 (m, 5H), 1.58 (d, J = 6.9 Hz, 3H, CH3), 1.51–1.44 (m, 2H), 1.34 (s, 3H, CH3), 1.23 (s, 6H, 2 × CH3), 1.21 (s, 3H, CH3). 13C NMR (100 MHz, CDCl3): δ 180.2, 179.6, 168.49, 146.1, 146.1, 136.2, 134.1, 129.3, 129.0, 126.9, 124.1, 123.9, 121.2, 55.1, 48.7, 45.2, 37.6, 37.1, 37.0, 33.4, 29.7, 25.1, 23.9, 21.5, 18.4, 16.5, 16.1. HR-MS (m/z) (ESI): calcd for C30H38ClN3O3S [M − H+]: 538.22950; found: 538.23074.
(1R,4aS)-7-Isopropyl-N-(((R)-1-((2-methoxyphenyl)amino)-1-oxopropan-2-yl)carbamothioyl)-1,4a-dimethyl-1,2,3,4,4a,9,10,10a-octahydrophenanthrene-1-carboxamide (8f). Yields 82.38%; 1H NMR (400 MHz, CDCl3): δ 11.19 (d, J = 7.3 Hz, 1H, NH), 8.61 (s, 1H, NH), 8.46 (s, 1H, NH), 8.37 (dd, J = 8.0, 1.5 Hz, 1H), 7.15 (d, J = 8.2 Hz, 1H), 7.05 (t, J = 7.0 Hz, 1H), 7.01 (d, J = 9.9 Hz, 1H), 6.95 (d, J = 9.0 Hz, 1H), 6.87 (d, J = 9.1 Hz, 2H), 5.11 (dd, J = 14.1, 7.0 Hz, 1H), 3.87 (s, 3H, OCH3), 2.97–2.77 (m, 3H), 2.33 (d, J = 13.3 Hz, 1H), 2.08 (d, J = 14.3 Hz, 1H), 1.83–1.67 (m, 5H), 1.62 (d, J = 7.0 Hz, 3H, CH3), 1.53–1.46 (m, 2H), 1.34 (s, 3H, CH3), 1.23 (s, 6H, 2 × CH3), 1.21 (s, 3H, CH3). 13C NMR (100 MHz, CDCl3): δ 179.4, 179.1, 168.4, 147.8, 146.1, 145.8, 134.1, 127.1, 126.8, 124.0, 123.9, 123.8, 120.9, 119.7, 109.9, 55.6, 55.5, 48.4, 45.0, 37.5, 36.9, 36.8, 33.3, 29.6, 25.0, 23.9, 21.3, 18.3, 17.5, 16.0. HR-MS (m/z) (ESI): calcd for C31H41N3O3S [M − H+]: 534.27903; found: 534.28014.
(1R,4aS)-7-Isopropyl-N-(((R)-1-((4-methoxyphenyl)amino)-1-oxopropan-2-yl)carbamothioyl)-1,4a-dimethyl-1,2,3,4,4a,9,10,10a-octahydrophenanthrene-1-carboxamide (8g). Yields 81.32%; 1H NMR (400 MHz, CDCl3): δ 11.13 (d, J = 7.4 Hz, 1H, NH), 8.59 (d, J = 3.1 Hz, 2H, NH), 7.46 (d, J = 9.0 Hz, 2H), 7.15 (d, J = 8.2 Hz, 1H), 7.01 (dd, J = 8.1, 1.7 Hz, 1H), 6.88 (d, J = 1.3 Hz, 1H), 6.84 (d, J = 9.0 Hz, 2H), 5.09–5.03 (m, 1H), 3.77 (s, 3H, OCH3), 2.94–2.80 (m, 3H), 2.33 (d, J = 13.2 Hz, 1H), 2.07 (dd, J = 13.0, 2.3 Hz, 1H), 1.80–1.67 (m, 5H), 1.58 (d, J = 6.9 Hz, 3H, CH3), 1.52–1.46 (m, 2H), 1.33 (s, 3H, CH3), 1.23 (s, 6H, 2× CH3), 1.21 (s, 3H, CH3). 13C NMR (100 MHz, CDCl3): δ 179.7, 179.3, 168.4, 156.3, 146.1, 145.9, 134.1, 130.7, 126.9, 124.0, 123.9, 121.6, 114.0, 55.4, 55.1, 48.5, 45.1, 37.5, 36.9, 36.9, 33.4, 29.6, 25.1, 23.9, 21.4, 18.4, 16.9, 16.0. HR-MS (m/z) (ESI): calcd for C31H41N3O3S [M − H+]: 534.27903; found: 534.28029.
(1R,4aS)-N-(((R)-1-((2-Fluorophenyl)amino)-1-oxopropan-2-yl)carbamothioyl)-7-isopropyl-1,4a-dimethyl-1,2,3,4,4a,9,10,10a-octahydrophenanthrene-1-carboxamide (8h). Yields 87.22%; 1H NMR (400 MHz, CDCl3): δ 11.14 (d, J = 7.4 Hz, 1H, NH), 8.65 (s, 1H, NH), 8.59 (s, 1H, NH), 8.30 (s, 1H), 7.15 (d, J = 8.2 Hz, 1H), 7.13–7.06 (m, 2H), 7.04 (s, 1H), 7.01 (d, J = 8.3 Hz, 1H), 6.88 (s, 1H), 5.16 (dd, J = 14.2, 7.1 Hz, 1H), 2.95–2.79 (m, 3H), 2.33 (d, J = 13.1 Hz, 1H), 2.07 (d, J = 1.7 Hz, 1H), 1.82–1.66 (m, 5H), 1.61 (d, J = 7.0 Hz, 3H, CH3), 1.51–1.44 (m, 2H), 1.33 (s, 3H, CH3), 1.22 (s, 6H, 2 × CH3), 1.21 (s, 3H, CH3). 13C NMR (100MHz, CDCl3): δ 179.9, 179.4, 168.8, 153.6, 151.1, 146.0, 145.9, 134.1, 126.8, 125.9, 125.8, 124.6, 124.5, 124.4, 124.3, 123.9, 123.8, 121.7, 121.2, 114.8, 114.6, 55.2, 48.5, 45.0, 37.4, 36.9, 36.8, 33.3, 29.6, 25.0, 23.8, 21.3, 18.3, 16.9, 16.0. HR-MS (m/z) (ESI): calcd for C30H38FN3O2S [M − H+]: 522.25905; found: 522.26047.
(1R,4aS)-N-(((R)-1-((4-Fluorophenyl)amino)-1-oxopropan-2-yl)carbamothioyl)-7-isopropyl-1,4a-dimethyl-1,2,3,4,4a,9,10,10a-octahydrophenanthrene-1-carboxamide (8i). Yields 81.26%; 1H NMR (400 MHz, CDCl3): δ 11.15 (d, J = 7.4 Hz, 1H, NH), 8.82 (s, 1H, NH), 8.63 (s, 1H, NH), 7.56–7.52 (m, 2H), 7.19 (d, J = 8.2 Hz, 1H), 7.06–6.99 (m, 3H), 6.91 (d, J = 1.4 Hz, 1H), 5.14–5.07 (m, 1H), 2.96–2.82 (m, 3H), 2.36 (d, J = 13.3 Hz, 1H), 2.11 (s, 1H), 1.84–1.66 (m, 5H), 1.61 (d, J = 6.9 Hz, 3H, CH3), 1.56–1.47 (m, 2H), 1.36 (s, 3H, CH3), 1.26 (s, 6H, 2 × CH3), 1.24 (s, 3H, CH3). 13C NMR (100 MHz, CDCl3): δ 178.0, 179.5, 168.6, 160.5, 158.1, 146.1, 146.0, 134.1, 133.6, 133.6, 126.9, 124.0, 123.9, 121.7, 121.6, 115.7, 115.4, 55.1, 48.6, 45.1, 37.5, 37.0, 36.9, 33.4, 29.6, 25.1, 23.9, 21.4, 18.4, 16.8, 16.0. HR-MS (m/z) (ESI): calcd for C30H38FN3O2S [M − H+]: 522.25905; found: 522.26019.
(1R,4aS)-N-(((R)-1-((2-Bromophenyl)amino)-1-oxopropan-2-yl)carbamothioyl)-7-isopropyl-1,4a-dimethyl-1,2,3,4,4a,9,10,10a-octahydrophenanthrene-1-carboxamide (8j). Yields 83.16%; 1H NMR (400 MHz, CDCl3): δ 11.17 (d, J = 7.3 Hz, 1H, NH), 8.69 (s, 1H, NH), 8.41 (s, 1H, NH), 8.35 (d, J = 8.3 Hz, 1H), 7.56 (d, J = 9.4 Hz, 1H), 7.33 (t, J = 8.5 Hz, 1H), 7.18 (d, J = 8.2 Hz, 1H), 7.06–6.99 (m, 2H), 6.91 (s, 1H), 5.21–5.15 (m, 1H), 2.96–2.81 (m, 3H), 2.36 (d, J = 13.4 Hz, 1H), 2.12 (d, J = 12.5 Hz, 1H), 1.85–1.70 (m, 5H), 1.66 (d, J = 7.0 Hz, 3H, CH3), 1.55–1.48 (m, 2H), 1.37 (s, 3H, CH3), 1.25 (s, 6H, 2 × CH3), 1.23 (s, 3H, CH3). 13C NMR (100 MHz, CDCl3): δ 180.1, 179.5, 168.8, 146.1, 146.0, 135.2, 134.1, 132.3, 128.2, 126.9, 125.5, 124.0, 123.9, 122.1, 113.7, 55.6, 48.6, 45.2, 37.5, 37.0, 36.9, 33.4, 29.7, 25.1, 23.9, 21.4, 18.4, 17.3, 16.1. HR-MS (m/z) (ESI): calcd for C30H38BrN3O2S [M + H+]: 584.19464; found: 584.19453.
(1R,4aS)-N-(((R)-1-((4-Bromophenyl)amino)-1-oxopropan-2-yl)carbamothioyl)-7-isopropyl-1,4a-dimethyl-1,2,3,4,4a,9,10,10a-octahydrophenanthrene-1-carboxamide (8k). Yields 82.19%; 1H NMR (400 MHz, CDCl3): δ 11.10 (d, J = 7.5 Hz, 1H, NH), 8.81 (s, 1H, NH), 8.63 (s, 1H, NH), 7.43 (d, J = 7.3 Hz, 2H), 7.15 (d, J = 8.2 Hz, 1H), 7.01 (d, J = 8.2 Hz, 1H), 6.88 (s, 1H), 6.55 (s, 2H), 5.10–5.05 (m, 1H), 2.92–2.78 (m, 3H), 2.33 (d, J = 13.3 Hz, 1H), 2.06 (d, J = 12.5 Hz, 1H), 1.81–1.65 (m, 5H), 1.57 (d, J = 6.9 Hz, 3H, CH3), 1.49–1.42 (m, 2H), 1.32 (s, 3H, CH3), 1.22 (d, J = 3.1 Hz, 6H, 2 × CH3), 1.21 (s, 3H, CH3). 13C NMR (100 MHz, CDCl3): δ 180.1, 179.6, 168.5, 146.1, 145.3, 136.7, 134.1, 131.1, 127.0, 123.9, 121.5, 116.6, 110.1, 55.1, 48.6, 45.1, 37.5, 37.0, 36.9, 33.4, 29.6, 25.1, 23.9, 21.4, 18.4, 16.5, 16.0. HR-MS (m/z) (ESI): calcd for C30H38BrN3O2S [M + H+]: 584.19464; found: 584.19565.
(1R,4aS)-N-(((R)-1-((3,5-Dimethylphenyl)amino)-1-oxopropan-2-yl)carbamothioyl)-7-isopropyl-1,4a-dimethyl-1,2,3,4,4a,9,10,10a-octahydrophenanthrene-1-carboxamide (8l). Yields 80.25%; 1H NMR (400 MHz, CDCl3): δ 11.11 (d, J = 7.5 Hz, 1H, NH), 8.59 (s, 1H, NH), 8.54 (s, 1H, NH), 7.19 (s, 2H), 7.15 (d, J = 8.2 Hz, 1H), 7.00 (d, J = 9.6 Hz, 1H), 6.88 (s, 1H), 6.74 (s, 1H), 5.07 (dd, J = 13.1, 6.0 Hz, 1H), 2.94–2.78 (m, 3H), 2.33 (d, J = 13.2 Hz, 1H), 2.27 (s, 6H, 2 × CH3), 2.07 (d, J = 14.2 Hz, 1H), 1.83–1.74 (m, 5H), 1.58 (d, J = 6.9 Hz, 3H, CH3)., 1.52–1.45 (m, 2H), 1.33 (s, 3H, CH3), 1.22 (s, 6H, 2 × CH3), 1.21 (s, 3H, CH3). 13C NMR (100 MHz, CDCl3): δ 179.5, 179.2, 168.7, 146.0, 145.7, 138.4, 137.3, 134.0, 126.7, 126.0, 123.8, 123.7, 117.6, 55.2, 53.3, 48.4, 44.9, 37.4, 36.8, 36.7, 33.2, 29.5, 24.9, 23.8, 21.1, 17.0, 15.8, 15.7. HR-MS (m/z) (ESI): calcd for C32H43N3O2S [M − H+]: 532.29977; found: 532.30120.
(1R,4aS)-7-Isopropyl-1,4a-dimethyl-N-(((R)-1-(naphthalen-1-ylamino)-1-oxopropan-2-yl)carbamothioyl)-1,2,3,4,4a,9,10,10a-octahydrophenanthrene-1-carboxamide (8m). Yields 88.15%; 1H NMR (400 MHz, CDCl3): δ 11.18 (d, J = 7.6 Hz, 1H, NH), 8.97 (s, 1H, NH), 8.66 (s, 1H, NH), 8.00 (d, J = 7.7 Hz, 2H), 7.82 (d, J = 8.5 Hz, 1H), 7.65 (d, J = 8.2 Hz, 1H), 7.50 (d, J = 6.8 Hz, 1H), 7.47 (d, J = 6.2 Hz, 1H), 7.43 (d, J = 7.9 Hz, 1H), 7.14 (d, J = 8.2 Hz, 1H), 7.01 (d, J = 9.8 Hz, 1H), 6.87 (s, 1H), 5.34–5.27 (m, 1H), 2.91–2.79 (m, 3H), 2.32 (d, J = 13.0 Hz, 1H), 2.07 (d, J = 12.4 Hz, 1H), 1.85–1.69 (m, 5H), 1.66 (d, J = 6.9 Hz, 3H, CH3), 1.50–1.43 (m, 2H), 1.32 (s, 3H, CH3), 1.22 (s, 3H, CH3), 1.21 (d, J = 1.8 Hz, 6H, 2 × CH3). 13C NMR (100 MHz, CDCl3: δ 179.9, 179.5, 169.2, 146.1, 145.9, 134.1, 133.9, 132.2, 128.5, 126.9, 126.6, 126.2, 125.9, 125.6, 125.5, 124.0, 123.9, 121.1, 120.2, 55.2, 48.5, 45.0, 37.5, 36.9, 36.9, 33.4, 29.6, 25.1, 23.9, 21.4, 18.4, 16.8, 16.0. HR-MS (m/z) (ESI): calcd for C34H41N3O2S [M − H+]: 554.28412; found: 554.28545.
(1R,4aS)-7-Isopropyl-1,4a-dimethyl-N-(((R)-1-oxo-1-(pyridin-2-ylamino)propan-2-yl)carbamothioyl)-1,2,3,4,4a,9,10,10a-octahydrophenanthrene-1-carboxamide (8n). Yields 81.03%; 1H NMR (400 MHz, CDCl3): δ 11.16 (s, 1H, NH), 9.37 (s, 1H, NH), 8.63 (s, 1H, NH), 8.35 (s, 1H), 8.23 (d, J = 8.2 Hz, 1H), 7.71 (d, J = 6.6 Hz, 1H), 7.15 (d, J = 8.2 Hz, 1H), 7.08 (d, J = 5.1 Hz, 1H), 7.01 (d, J = 8.1 Hz, 1H), 6.88 (s, 1H), 5.09 (dd, J = 12.2, 5.3 Hz, 1H), 2.94–2.79 (m, 3H), 2.34 (d, J = 13.4 Hz, 1H), 2.08 (d, J = 10.6 Hz, 1H), 1.88–1.70 (m, 5H), 1.60 (d, J = 7.2 Hz, 3H, CH3), 1.52–1.46 (m, 2H), 1.34 (s, 3H, CH3), 1.23 (d, J = 2.7 Hz, 6H, 2 × CH3), 1.21 (s, 3H, CH3). 13C NMR (100 MHz, CDCl3): δ 180.1, 179.4, 169.5, 151.1, 147.8, 146.2, 146.0, 138.5, 134.2, 126.9, 124.0, 123.9, 120.1, 114.5, 55.6, 53.4, 48.6, 45.1, 37.6, 37.0, 33.4, 29.6, 25.1, 23.9, 21.4, 18.4, 17.5, 16.1. HR-MS (m/z) (ESI): calcd for C29H38N4O2S [M − H+]: 505.26372; found: 505.26356.
(1R,4aS)-7-Isopropyl-1,4a-dimethyl-N-(((R)-1-oxo-1-((3,4,5-trimethoxyphenyl)amino)propan-2-yl)carbamothioyl)-1,2,3,4,4a,9,10,10a-octahydrophenanthrene-1-carboxamide (8o). Yields 82.06%; 1H NMR (400 MHz, CDCl3): δ 11.12 (d, J = 7.5 Hz, 1H, NH), 8.72 (s, 1H, NH), 8.59 (s, 1H, NH), 7.16 (d, J = 8.2 Hz, 1H), 7.01 (d, J = 8.2 Hz, 1H), 6.88 (s, 3H), 5.07 (dd, J = 14.2, 7.0 Hz, 1H), 3.84 (s, 6H, 2 × OCH3), 3.81 (s, 3H, OCH3), 2.94–2.79 (m, 3H), 2.34 (d, J = 13.3 Hz, 1H), 2.07 (dd, J = 12.5, 1.7 Hz, 1H), 1.85–1.66 (m, 5H), 1.59 (d, J = 6.9 Hz, 3H, CH3), 1.52–1.45 (m, 2H), 1.34 (s, 3H, CH3), 1.23 (s, 6H, 2 × CH3), 1.21 (s, 3H, CH3).13C NMR (100 MHz, CDCl3): δ 179.9, 179.5, 168.5, 153.2, 146.1, 146.0, 134.5, 134.1, 133.8, 126.9, 124.0, 123.9, 97.3, 60.9, 56.0, 55.2, 48.6, 45.1, 37.5, 37.0, 36.9, 33.4, 29.6, 25.1, 23.9, 21.4, 18.4, 16.7, 16.0. HR-MS (m/z) (ESI): calcd for C33H45N3O5S [M − H+]: 594.30016; found: 594.30143.
(1R,4aS)-7-Isopropyl-1,4a-dimethyl-N-(((R)-1-oxo-3-phenyl-1-(phenylamino)propan-2-yl)carbamothioyl)-1,2,3,4,4a,9,10,10a-octahydrophenanthrene-1-carboxamide (9a). Yields 89.23%, 1H NMR (400 MHz, CDCl3): δ 11.29 (d, J = 7.4 Hz, 1H, NH), 8.56 (s, 1H, NH), 7.92 (s, 1H), 7.35 (d, J = 7.6 Hz, 2H), 7.30–7.28 (m, 3H), 7.23 (s, 2H), 7.21 (s, 1H), 7.13 (d, J = 8.2 Hz, 1H), 7.05 (d, J = 7.4 Hz, 1H), 7.00 (d, J = 8.2 Hz, 1H), 6.87 (s, 1H), 5.20 (dd, J = 14.2, 7.6 Hz, 1H). 3.41–3.35 (m, 1H), 3.24–3.19 (m, 1H), 2.89–2.78 (m, 3H), 2.30 (d, J = 13.2 Hz, 1H), 2.01 (d, J = 12.5 Hz, 1H), 1.76–1.39 (m, 7H), 1.27 (s, 3H, CH3), 1.21 (d, J = 6.9 Hz, 6H, 2 × CH3), 1.19 (s, 3H, CH3). 13C NMR (100 MHz, CDCl3): δ 179.5, 178.9, 167.4, 146.0, 145.6, 136.9, 135.9, 133.9, 129.2, 128.6, 128.4, 126.9, 126.7, 124.3, 123.8, 123.7, 119.9, 61.2, 48.2, 44.9, 37.4, 37.3, 36.7, 36.5, 33.2, 29.4, 24.8, 23.7, 21.0, 18.2, 15.7. HR-MS (m/z) (ESI): calcd for C36H43N3O2S [M − H+]: 580.29977; found: 580.30102.
(1R,4aS)-7-Isopropyl-1,4a-dimethyl-N-(((R)-1-oxo-3-phenyl-1-(o-tolylamino)propan-2-yl)carbamothioyl)-1,2,3,4,4a,9,10,10a-octahydrophenanthrene-1-carboxamide (9b). Yields 88.24%, 1H NMR (400 MHz, CDCl3): δ 11.27 (d, J = 7.5 Hz, 1H, NH), 8.59 (s, 1H, NH), 7.87 (d, J = 8.0 Hz, 1H), 7.53 (s, 1H), 7.32 (d, J = 9.8 Hz, 4H), 7.15 (d, J = 8.2 Hz, 2H), 7.10 (d, J = 6.8 Hz, 1H), 7.01 (d, J = 8.4 Hz, 2H), 6.88 (d, J = 1.4 Hz, 1H), 5.26 (dd, J = 14.5, 8.1 Hz, 1H), 3.42–3.35 (m, 1H), 3.29–3.22 (m, 1H), 2.90–2.79 (m, 3H), 2.33 (d, J = 13.3 Hz, 1H), 2.06 (d, J = 12.5 Hz, 1H), 1.98 (s, 3H, CH3), 1.75–1.45 (m, 7H), 1.32 (s, 3H, CH3), 1.22 (d, J = 3.5 Hz, 6H, 2 × CH3), 1.21 (s, 3H, CH3). 13C NMR (100 MHz, CDCl3): δ 179.9, 179.1, 167.4, 157.5, 146.1, 145.9, 136.1, 135.2, 134.1, 130.2, 129.2, 128.7, 127.1, 126.8, 126.5, 125.0, 123.8, 122.3, 121.2, 61.3, 48.4, 45.1, 37.5, 37.3, 36.9, 36.7, 33.3, 29.6, 25.0, 23.8, 21.2, 18.3, 17.5, 15.9. HR-MS (m/z) (ESI): calcd for C37H45N3O2S [M − H+]: 618.31302; found: 618.31195.
(1R,4aS)-7-Isopropyl-1,4a-dimethyl-N-(((R)-1-oxo-3-phenyl-1-(p-tolylamino)propan-2-yl)carbamothioyl)-1,2,3,4,4a,9,10,10a-octahydrophenanthrene-1-carboxamide (9c). Yields 87.14%, 1H NMR (400 MHz, CDCl3): δ 11.28 (d, J = 7.4 Hz, 1H, NH), 8.56 (s, 1H, NH), 7.63 (s, 1H), 7.32 (d, J = 4.8 Hz, 4H), 7.23 (d, J = 8.5 Hz, 2H), 7.15 (d, J = 8.2 Hz, 1H), 7.06 (d, J = 8.2 Hz, 2H), 7.01 (dd, J = 8.1, 1.7 Hz, 1H), 6.88 (d, J = 1.3 Hz, 1H), 5.16 (dd, J = 14.3, 7.8 Hz, 1H), 3.42–3.36 (m, 1H), 3.23–3.17 (m, 1H), 2.90–2.79 (m, 3H), 2.28 (s, 3H, CH3), 2.03 (d, J = 1.9 Hz, 1H), 1.76–1.45 (m, 7H), 1.31 (s, 3H, CH3), 1.23 (d, J = 4.1 Hz, 6H, 2 × CH3), 1.21 (s, 3H, CH3). 13C NMR (100 MHz, CDCl3): δ 179.8, 179.1, 167.2, 146.2, 145.9, 136.3, 136.2, 134.5, 134.1, 129.3, 128.7, 127.1, 126.9, 124.0, 123.9, 120.1, 119.8, 61.4, 48.5, 45.2, 37.6, 37.5, 37.0, 36.8, 33.4, 29.6, 25.0, 23.9, 21.2, 20.8, 18.4, 16.0. HR-MS (m/z) (ESI): calcd for C37H45N3O2S [M − H+]: 594.31542; found: 594.31687.
(1R,4aS)-N-(((R)-1-((2-Chlorophenyl)amino)-1-oxo-3-phenylpropan-2-yl)carbamothioyl)-7-isopropyl-1,4a-dimethyl-1,2,3,4,4a,9,10,10a-octahydrophenanthrene-1-carboxamide (9d). Yields 82.46%, 1H NMR (400 MHz, CDCl3): δ 11.29 (d, J = 7.4 Hz, 1H, NH), 8.62 (s, 1H, NH), 8.37 (d, J = 8.3 Hz, 1H, NH), 8.00 (s, 1H), 7.30 (d, J = 6.0 Hz, 4H), 7.27 (d, J = 1.4 Hz, 1H), 7.25–7.21 (m, 2H), 7.15 (d, J = 8.2 Hz, 1H), 7.03–6.98 (m, 2H), 6.88 (d, J = 1.4 Hz, 1H), 5.29 (dd, J = 14.2, 7.5 Hz, 1H), 3.43–3.37 (m, 1H), 3.28–3.21 (m, 1H), 2.91–2.79 (m, 3H), 2.33 (d, J = 13.1 Hz, 1H), 2.07 (d, J = 10.6 Hz, 1H), 1.77–1.39 (m, 7H), 1.32 (s, 3H, CH3), 1.22 (d, J = 4.0 Hz, 6H, 2 × CH3), 1.21 (s, 3H, CH3). 13C NMR (100 MHz, CDCl3): δ 180.0, 179.1, 167.5, 146.1, 145.7, 135.7, 134.0, 133.9, 129.1, 128.8, 128.7, 127.4, 127.1, 126.5, 124.8, 123.9, 123.8, 122.8, 121.5, 61.5, 48.4, 45.1, 37.5, 37.4, 36.8, 36.7, 33.3, 29.5, 24.9, 23.8, 21.2, 18.3, 15.9. HR-MS (m/z) (ESI): calcd for C36H42ClN3O2S [M + Na+]: 638.25840; found: 638.25879.
(1R,4aS)-N-(((R)-1-((4-Chlorophenyl)amino)-1-oxo-3-phenylpropan-2-yl)carbamothioyl)-7-isopropyl-1,4a-dimethyl-1,2,3,4,4a,9,10,10a-octahydrophenanthrene-1-carboxamide (9e). Yields 85.78%, 1H NMR (400 MHz, CDCl3): δ 11.27 (d, J = 7.4 Hz, 1H, NH), 8.56 (s, 1H, NH), 7.86 (s, 1H), 7.32 (s, 1H), 7.31 (s, 3H), 7.29 (d, J = 3.3 Hz, 2H), 7.23 (d, J = 8.7 Hz, 2H), 7.15 (d, J = 8.2 Hz, 1H), 7.01 (d, J = 8.1 Hz, 1H), 6.89 (s, 1H), 5.17 (dd, J = 14.7, 7.4 Hz, 1H), 3.42–3.35 (m, 1H), 3.25–3.18 (m, 1H), 2.96–2.76 (m, 3H), 2.34 (d, J = 13.1 Hz, 1H), 2.04 (d, J = 11.1 Hz, 1H), 1.77–1.42 (m, 7H), 1.31 (s, 3H, CH3), 1.23 (d, J = 3.6 Hz, 6H, 2 × CH3), 1.22 (s, 3H, CH3). 13C NMR (100 MHz, CDCl3): δ 180.2, 179.3, 167.4, 146.2, 146.1, 136.1, 135.7, 134.1, 129.3, 128.9, 128.8, 127.3, 126.9, 124.1, 124.0, 123.9, 121.2, 61.4, 48.6, 45.3, 37.6, 37.3, 37.0, 36.9, 33.5, 29.7, 25.1, 23.9, 21.3, 18.5, 16.0. HR-MS (m/z) (ESI): calcd for C36H42ClN3O2S [M − H+]: 614.26080; found: 614.26064.
(1R,4aS)-7-Isopropyl-N-(((R)-1-((2-methoxyphenyl)amino)-1-oxo-3-phenylpropan-2-yl)carbamothioyl)-1,4a-dimethyl-1,2,3,4,4a,9,10,10a-octahydrophenanthrene-1-carboxamide (9f). Yields 80.28%, 1H NMR (400 MHz, CDCl3): δ 11.39 (d, J = 7.3 Hz, 1H, NH), 8.64 (s, 1H, NH), 8.41 (d, J = 9.3 Hz, 1H, NH), 7.94 (s, 1H), 7.37 (d, J = 6.8 Hz, 3H), 7.33 (s, 1H), 7.31 (d, J = 3.9 Hz, 1H), 7.20 (d, J = 8.2 Hz, 1H), 7.07–7.04 (m, 2H), 6.97 (d, J = 7.7 Hz, 1H), 6.93 (s, 1H), 6.82 (d, J = 8.1 Hz, 1H), 5.26 (dd, J = 13.8, 7.8 Hz, 1H), 3.72 (s, 3H, OCH3), 3.52–3.47 (m, 1H), 3.25–3.19 (m, 1H), 2.95–2.84 (m, 3H), 2.38 (d, J = 13.0 Hz, 1H), 2.12 (d, J = 12.4 Hz, 1H), 1.78–1.49 (m, 7H), 1.38 (s, 3H, CH3), 1.28 (d, J = 3.0 Hz, 6H, 2 × CH3), 1.26 (s, 3H, CH3). 13C NMR (100 MHz, CDCl3): δ 179.5, 178.9, 167.1, 147.7, 146.1, 145.8, 136.1, 134.1, 129.2, 128.5, 126.9, 126.8, 123.9, 123.8, 120.9, 120.7, 120.7, 119.6, 109.8, 61.7, 55.4, 48.4, 45.1, 37.8, 37.5, 36.9, 36.8, 33.3, 29.5, 24.9, 23.8, 21.2, 18.3, 15.9. HR-MS (m/z) (ESI): calcd for C36H45N3O3S [M − H+]: 610.31033; found: 610.31051.
(1R,4aS)-7-Isopropyl-N-(((R)-1-((4-methoxyphenyl)amino)-1-oxo-3-phenylpropan-2-yl)carbamothioyl)-1,4a-dimethyl-1,2,3,4,4a,9,10,10a-octahydrophenanthrene-1-carboxamide (9g). Yields 81.57%, 1H NMR (400 MHz, CDCl3): δ 11.29 (d, J = 7.4 Hz, 1H, NH), 8.55 (s, 1H, NH), 7.54 (s, 1H), 7.33 (d, J = 4.4 Hz, 4H), 7.26 (s, 1H), 7.24 (s, 1H), 7.16 (d, J = 8.2 Hz, 1H), 7.01 (d, J = 6.5 Hz, 1H), 6.89 (s, 1H), 6.80 (d, J = 9.0 Hz, 2H), 5.14 (dd, J = 14.4, 7.8 Hz, 1H), 3.77 (s, 3H, OCH3), 3.42–3.38 (m, 1H), 3.23–3.17 (m, 1H), 2.89–2.79 (m, 3H), 2.33 (d, J = 13.1 Hz, 1H), 2.05 (d, J = 12.4 Hz, 1H), 1.73–1.43 (m, 7H), 1.32 (s, 3H, CH3), 1.23 (d, J = 2.8 Hz, 6H, 2 × CH3), 1.22 (s, 3H, CH3). 13C NMR (100 MHz, CDCl3): δ 179.8, 179.2, 167.1, 156.5, 146.2, 146.0, 136.3, 134.2, 130.1, 129.4, 128.8, 127.2, 126.9, 124.0, 123.9, 121.8, 114.0, 61.5, 55.4, 48.6, 45.2, 37.6, 37.5, 37.0, 36.9, 33.4, 29.6, 25.1, 23.9, 21.3, 18.4, 16.04. HR-MS (m/z) (ESI): calcd for C36H45N3O3S [M + Na+]: 634.30793; found: 634.30579.
(1R,4aS)-N-(((R)-1-((2-Fluorophenyl)amino)-1-oxo-3-phenylpropan-2-yl)carbamothioyl)-7-isopropyl-1,4a-dimethyl-1,2,3,4,4a,9,10,10a-octahydrophenanthrene-1-carboxamide (9h). Yields 85.27%, 1H NMR (400 MHz, CDCl3): δ 11.30 (d, J = 9.9 Hz, 1H, NH), 8.60 (s, 1H, NH), 8.26 (s, 1H, NH), 7.91 (dd, J = 13.0, 2.3 Hz, 1H), 7.30 (s, 3H), 7.28–7.21 (m, 2H), 7.15 (d, J = 8.2 Hz, 1H), 7.11–7.05 (m, 1H), 7.01 (d, J = 4.4 Hz, 2H), 6.99 (d, J = 1.6 Hz, 1H), 6.88 (d, J = 5.4 Hz, 1H), 5.26 (dd, J = 12.6, 5.2 Hz, 1H), 3.42–3.35(m, 1H), 3.28–3.22 (m, 1H), 2.92–2.79 (m, 3H), 2.32 (d, J = 13.3 Hz, 1H), 2.09–2.02 (m, 1H), 1.76–1.41 (m, 7H), 1.31 (s, 3H, CH3), 1.23 (d, J = 2.5 Hz, 3H, CH3), 1.21 (d, J = 2.2 Hz, 6H, 2 × CH3).13C NMR (100MHz, CDCl3): δ 179.9, 179.0, 167.6, 153.2, 151.3, 146.1, 145.7, 135.7, 134.0, 129.1, 128.5, 127.0, 126.7, 125.5, 125.4, 124.6, 124.5, 124.2, 124.1, 123.8, 123.7, 123.6, 121.8, 114.7, 114.5, 61.2, 48.3, 45.0, 37.4, 37.3, 36.8, 36.6, 33.2, 29.5, 24.9, 23.8, 21.1, 18.3, 15.8. HR-MS (m/z) (ESI): calcd for C36H42FN3O2S [M − H+]: 598.29035; found: 598.29175.
(1R,4aS)-N-(((R)-1-((4-Fluorophenyl)amino)-1-oxo-3-phenylpropan-2-yl)carbamothioyl)-7-isopropyl-1,4a-dimethyl-1,2,3,4,4a,9,10,10a-octahydrophenanthrene-1-carboxamide (9i). Yields 80.13%, 1H NMR (400 MHz, CDCl3): δ 11.35 (d, J = 7.3 Hz, 1H, NH). 8.63 (s, 1H, NH), 8.03 (s, 1H, NH), 7.38 (d, J = 4.8 Hz, 1H), 7.37 (s, 3H), 7.32 (dd, J = 9.3, 4.1 Hz, 2H), 7.21 (d, J = 8.2 Hz, 1H), 7.08 (d, J = 9.7 Hz, 1H), 7.00 (d, J = 8.6 Hz, 2H), 6.96 (s, 1H), 6.94 (s, 1H), 5.25 (dd, J = 14.5, 7.4 Hz, 1H), 3.55–3.38 (m, 1H), 3.33–3.23 (m, 1H), 2.95–2.87 (m, 3H), 2.38 (d, J = 13.2 Hz, 1H), 2.08 (d, J = 12.5 Hz, 1H), 1.80–1.47 (m, 7H), 1.35 (s, 3H, CH3), 1.29 (d, J = 6.9 Hz, 6H, 2 × CH3), 1.27 (s, 3H, CH3).13C NMR (100 MHz, CDCl3): δ 179.7, 179.0, 167.5, 160.2, 158.3, 146.0, 145.7, 135.9, 133.9, 132.9, 129.1, 128.5, 127.0, 126.7, 123.9, 123.8, 121.8, 115.4, 115.2, 61.2, 48.4, 45.1, 37.4, 36.8, 36.8, 36.6, 33.3, 29.5, 24.9, 23.7, 21.1, 18.3, 15.8. HR-MS (m/z) (ESI): calcd for C36H42FN3O2S [M − H+]: 598.29035; found: 598.29118.
(1R,4aS)-N-(((R)-1-((2-Bromophenyl)amino)-1-oxo-3-phenylpropan-2-yl)carbamothioyl)-7-isopropyl-1,4a-dimethyl-1,2,3,4,4a,9,10,10a-octahydrophenanthrene-1-carboxamide (9j). Yields 88.33%, 1H NMR (400 MHz, CDCl3): δ 11.21 (d, J = 7.4 Hz, 1H, NH), 8.54 (s, 1H, NH), 8.28 (d, J = 8.3 Hz, 1H, NH), 7.91 (s, 1H), 7.21 (d, J = 6.0 Hz, 4H), 7.19 (d, J = 1.4 Hz, 1H), 7.17–7.12 (m, 2H), 7.07 (d, J = 8.2 Hz, 1H), 6.95–6.90 (m, 2H), 6.80 (d, J = 1.4 Hz, 1H), 5.21 (dd, J = 14.2, 7.5 Hz, 1H), 3.35–3.28 (m, 1H), 3.20–3.13 (m, 1H), 2.83–2.71 (m, 3H), 2.24 (d, J = 13.1 Hz, 1H), 1.99 (d, J = 10.6 Hz, 1H), 1.69–1.30 (m, 7H), 1.24 (s, 3H, CH3), 1.14 (d, J = 4.0 Hz, 6H, 2 × CH3), 1.13 (s, 3H, CH3). 13C NMR (100 MHz, CDCl3): δ 180.0, 179.2, 167.5, 146.1, 145.8, 135.7, 134.0, 133.9, 129.1, 128.8, 128.7, 127.4, 127.1, 126.8, 124.8, 123.9, 123.8, 122.8, 121.5, 61.5, 48.4, 45.1, 37.5, 37.4, 36.9, 36.7, 33.3, 29.6, 24.9, 23.8, 21.2, 18.3, 16.0. HR-MS (m/z) (ESI): calcd for C36H42BrN3O2S [M + H+]: 660.22594; found: 660.22639.
(1R,4aS)-N-(((R)-1-((4-Bromophenyl)amino)-1-oxo-3-phenylpropan-2-yl)carbamothioyl)-7-isopropyl-1,4a-dimethyl-1,2,3,4,4a,9,10,10a-octahydrophenanthrene-1-carboxamide (9k). Yields 82.34%, 1H NMR (400 MHz, CDCl3): δ 11.32 (d, J = 7.4 Hz, 1H, NH), 8.60 (s, 1H, NH), 7.98 (s, 1H, NH), 7.40 (d, J = 8.8 Hz, 2H), 7.34 (d, J = 3.6 Hz, 4H), 7.33–7.31 (m, 1H), 7.29 (d, J = 8.9 Hz, 2H), 7.19 (d, J = 8.2 Hz, 1H), 7.05 (d, J = 8.2 Hz, 1H), 6.92 (s, 1H), 5.22 (dd, J = 14.6, 7.4 Hz, 1H), 3.45–3.39 (m, 1H), 3.28–3.21 (m, 1H), 2.94–2.83 (m, 3H), 2.37 (d, J = 13.1 Hz, 1H), 2.06 (d, J = 14.1 Hz, 1H), 1.82–1.44 (m, 7H), 1.34 (s, 3H, CH3), 1.27 (s, 3H, CH3), 1.26 (s, 6H, 2 × CH3). 13C NMR (100 MHz, CDCl3): δ 179.9, 179.2, 167.5, 146.1, 145.9,136.1, 136.0, 134.1, 131.8, 129.3, 128.7, 127.2, 126.8, 124.0, 123.9, 121.5, 117.1, 61.4, 48.5, 45.1, 37.5, 37.4, 36.9, 36.8, 33.4, 29.6, 25.0, 23.9, 21.2, 18.4, 15.9. HR-MS (m/z) (ESI): calcd for C36H42BrN3O2S [M + H+]: 660.22594; found: 660.22566.
(1R,4aS)-N-(((R)-1-((3,5-Dimethylphenyl)amino)-1-oxo-3-phenylpropan-2-yl)carbamothioyl)-7-isopropyl-1,4a-dimethyl-1,2,3,4,4a,9,10,10a-octahydrophenanthrene-1-carboxamide (9l). Yields 82.57%, 1H NMR (400 MHz, CDCl3): δ 11.34 (d, J = 7.4 Hz, 1H, NH), 8.62 (s, 1H, NH), 7.76 (s, 1H), 7.37 (d, J = 4.6 Hz, 4H), 7.20 (d, J = 8.2 Hz, 1H), 7.05 (s, 3H), 6.94 (s, 1H), 6.78 (s, 1H), 5.23 (dd, J = 14.4, 7.5 Hz, 1H), 3.47–3.41 (m, 1H), 3.31–3.25 (m, 1H), 2.94–2.84 (m, 3H), 2.30 (s, 6H, 2 × CH3), 1.82–1.51 (m, 7H), 1.36 (s, 3H, CH3), 1.29 (s, 3H, CH3), 1.27 (s, 6H, 2 × CH3). 13C NMR (100 MHz, CDCl3): δ 179.9, 179.2, 167.2, 146.2, 146.0, 138.6, 136.9, 136.3, 134.2, 129.3, 128.8, 127.1, 126.9, 126.3, 124.0, 123.9, 117.7, 61.5, 48.5, 45.2, 37.6, 37.4, 37.0, 36.9, 33.4, 29.6, 25.0, 23.9, 21.3, 21.2, 18.4, 16.0. HR-MS (m/z) (ESI): calcd for C38H47N3O2S [M − H+]: 608.33107; found: 608.33232.
(1R,4aS)-7-Isopropyl-1,4a-dimethyl-N-(((R)-1-(naphthalen-1-ylamino)-1-oxo-3-phenylpropan-2-yl)carbamothioyl)-1,2,3,4,4a,9,10,10a-octahydrophenanthrene-1-carboxamide (9m). Yields 84.09%, 1H NMR (400 MHz, CDCl3): δ 11.34 (d, J = 7.5 Hz, 1H, NH), 8.62 (s, 1H, NH), 8.18 (s, 1H, NH), 7.94 (d, J = 7.5 Hz, 1H), 7.79 (d, J = 8.0 Hz, 1H), 7.64 (d, J = 8.2 Hz, 1H), 7.42 (d, J = 8.0 Hz, 2H), 7.38 (d, J = 5.8 Hz, 4H), 7.35–7.30 (m, 3H), 7.15 (d, J = 8.2 Hz, 1H), 7.01 (d, J = 8.0 Hz, 1H), 6.88 (s, 1H), 5.42 (dd, J = 14.6, 7.4 Hz, 1H), 3.43 (d, J = 6.4 Hz, 1H), 3.35–3.28 (m, 1H), 2.89–2.78 (m, 3H), 2.32 (d, J = 13.2 Hz, 1H), 2.07 (s, 1H), 1.75–1.43 (m, 7H), 1.30 (s, 3H, CH3), 1.23 (s, 3H, CH3), 1.21 (s, 6H, 2 × CH3). 13C NMR (100 MHz, CDCl3): δ 180.2, 179.3, 168.0, 146.2, 146.1, 136.3, 134.2, 133.9, 131.8, 129.4, 129.0, 128.5, 127.2, 126.9, 126.5, 126.2, 125.9, 125.7, 125.6, 124.1, 123.9, 120.9, 120.1, 61.6, 48.6, 45.2, 37.6, 37.5, 37.0, 36.9, 33.4, 29.7, 25.1, 23.9, 21.3, 18.5, 16.1. HR-MS (m/z) (ESI): calcd for C40H45N4O2S [M − H+]: 630.31542; found: 630.31666.
(1R,4aS)-7-Isopropyl-1,4a-dimethyl-N-(((R)-1-oxo-3-phenyl-1-(pyridin-2-ylamino)propan-2-yl)carbamothioyl)-1,2,3,4,4a,9,10,10a-octahydrophenanthrene-1-carboxamide (9n). Yields 88.56%, 1H NMR (400 MHz, CDCl3): δ 11.19 (d, J = 7.1 Hz, 1H, NH), 9.09 (s, 1H, NH), 8.57 (s, 1H), 8.23 (d, J = 6.3 Hz, 2H), 7.71 (s, 1H), 7.25 (d, J = 3.7 Hz, 4H), 7.15 (d, J = 8.2 Hz, 1H), 7.06 (d, J = 5.9 Hz, 1H), 7.01 (d, J = 8.2 Hz, 1H), 6.89 (s, 1H), 5.23 (dd, J = 14.3, 7.8 Hz, 1H), 3.35–3.26 (m, 2H), 2.90–2.80 (m, 3H), 2.33 (d, J = 13.3 Hz, 1H), 2.05 (d, J = 12.5 Hz, 1H), 1.76–1.49 (m, 7H), 1.31 (s, 3H, CH3), 1.23 (d, J = 3.5 Hz, 6H, 2 × CH3), 1.22 (s, 3H, CH3). 13C NMR (100 MHz, CDCl3): δ 180.4, 178.9, 168.3, 150.8, 147.5, 146.2, 146.0, 138.5, 135.7, 134.2, 129.3, 128.6, 127.2, 126.9, 124.0, 123.9, 120.0, 114.5, 61.6, 48.5, 45.1, 37.7, 37.6, 37.0, 36.9, 33.4, 29.6, 25.0, 23.9, 21.3, 18.4, 16.0. HR-MS (m/z) (ESI): calcd for C37H42N4O2S [M + H+]: 583.31067; found: 583.3098.
(1R,4aS)-7-Isopropyl-1,4a-dimethyl-N-(((R)-1-oxo-3-phenyl-1-((3,4,5-trimethoxyphenyl)amino)propan-2-yl)carbamothioyl)-1,2,3,4,4a,9,10,10a-octahydrophenanthrene-1-carboxamide (9o). Yields 85.32%, 1H NMR (400 MHz, CDCl3): δ 11.32 (d, J = 7.3 Hz, 1H, NH), 8.59 (s, 1H, NH), 7.80 (s, 1H), 7.34 (d, J = 4.4 Hz, 4H), 7.17 (d, J = 8.2 Hz, 1H), 7.03 (d, J = 8.2 Hz, 1H), 6.90 (s, 1H), 6.67 (s, 2H), 5.19 (dd, J = 14.5, 7.4 Hz, 1H), 3.81 (s, 12H, 3 × OCH3), 3.45–3.40 (m, 1H), 3.27–3.21 (m, 1H), 2.92–2.81 (m, 3H), 2.35 (d, J = 13.2 Hz, 1H), 2.06 (d, J = 10.8 Hz, 1H), 1.78–1.48 (m, 7H), 1.33 (s, 3H, CH3), 1.24 (d, J = 4.6 Hz, 6H, 2 × CH3), 1.23 (s, 3H, CH3). 13C NMR (100 MHz, CDCl3): δ 179.8, 179.2, 167.3, 153.0, 146.0, 145.9, 136.1, 134.6, 134.0, 133.1, 129.3, 128.7, 127.0, 126.8, 124.0, 123.8, 97.4, 61.4, 60.8, 55.9, 48.5, 45.1, 37.5, 37.4, 36.9, 36.8, 33.3, 29.5, 24.9, 23.8, 21.2, 18.3, 15.9. HR-MS (m/z) (ESI): calcd for C39H49N3O5S [M − H+]: 670.33146; found: 670.33304.